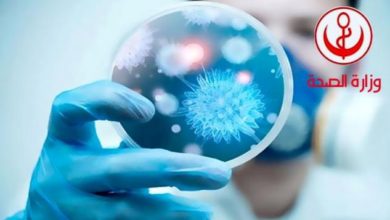

حالات الوفيات
-
أهم الأحداث

الجولان ممنوع اليوم في شارع الحبيب بورقيبة… في هذه الأوقات
تونس ــ الرأي الجديد قررت وزارة الدّاخليّة، منع جولان عن جميع أصناف العربات بشارع الحبيب بورقيبة بالعاصمة في جزئه الممتدّ…
أكمل القراءة » -
أهم الأحداث

منظمة الصحة العالمية تعلن عن اقتراب موعد نهاية المرحلة الخطيرة من فيروس “كورونا”
تونس ــ الرأي الجديد أعلنت منظمة الصحة العالمية، أمس، أن المرحلة الحادة من جائحة “كورونا”، ربما انتهت العام 2022. وأوضحت…
أكمل القراءة » -
أهم الأحداث

وزارة الصحة: أعداد الوفيات والإصابات في تراجع لافت يومي عيد الأضحى
تونس ــ الرأي الجديد / فتحي الغانمي أعلنت وزارة الصحة، عن تسجيل 92 حالة وفاة فقط خلال يوم أمس الأول…
أكمل القراءة » -
أهم الأحداث

أكثر من 2000 وفاة بكوفيد ـ 19 في تونس منذ الموجة الأولى
تونس ــ الرأي الجديد (متابعات) قال بلاغ لوزارة الصحة، أنه تم تسجيل 15 حالة وفاة جديدة بفيروس كورونا يوم 9…
أكمل القراءة » -
أهم الأحداث
الوضع الوبائي في تونس: 8 إصابات جديدة بـ “كورونا”.. والوفيات ترتفع إلى 40 حالة
تونس ــ الرأي الجديد / حمدي بالناجح أعلنت وزارة الصحة عن تسجيل 8 إصابات جديدة بفيروس “كورونا”، بعد إجراء 396 تحليلا…
أكمل القراءة »
